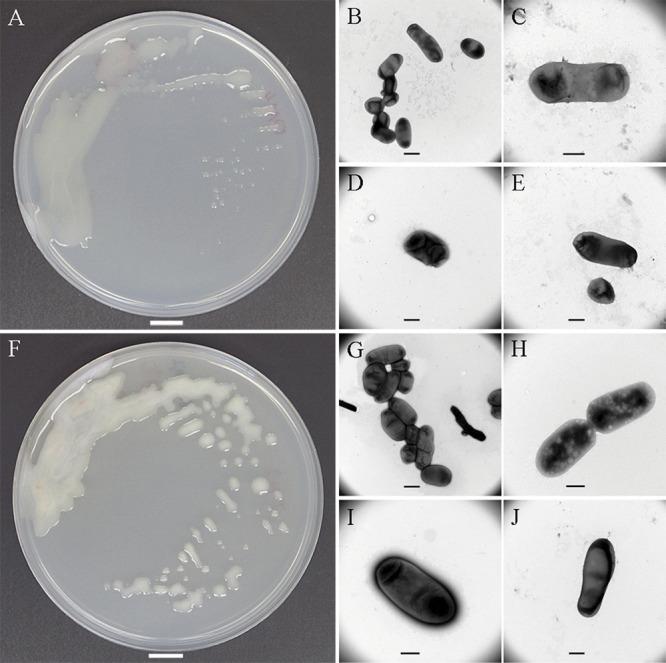
https://cdn.ncbi.nlm.nih.gov/pmc/blobs/9645/9603459/08bbefa083ca/spectrum.01099-22-f005.jpg

从普通苦马豆(Onobrychis viciifolia)根瘤中分离出的两个新种表现出不同的植物定植策略。
Two New Species Isolated from Root Nodules of Common Sainfoin (Onobrychis viciifolia) Show Different Plant Colonization Strategies.
机构信息
Julius Kühn Institute (JKI)-Federal Research Centre for Cultivated Plants, Institute for Epidemiology and Pathogen Diagnostics, Braunschweig, Germany.
Julius Kühn Institute (JKI)-Federal Research Centre for Cultivated Plants, Institute for Plant Protection in Horticulture and Forests, Braunschweig, Germany.
出版信息
Microbiol Spectr. 2022 Oct 26;10(5):e0109922. doi: 10.1128/spectrum.01099-22. Epub 2022 Aug 25.
Root nodules of legume plants are primarily inhabited by rhizobial nitrogen-fixing bacteria. Here, we propose two new species isolated from root nodules of common sainfoin (Onobrychis viciifolia), as shown by core-gene phylogeny, overall genome relatedness indices, and pan-genome analysis. Mesorhizobium onobrychidis sp. nov. actively induces nodules and achieves atmospheric nitrogen and carbon dioxide fixation. This species appears to be depleted in motility genes and is enriched in genes for direct effects on plant growth performance. Its genome reveals functional and plant growth-promoting signatures, like a large unique chromosomal genomic island with high density of symbiotic genetic traits. Onobrychidicola muellerharveyae gen. nov. sp. nov. is described as a type species of the new genus in . This species comprises unique genetic features and plant growth-promoting traits (PGPTs), which strongly indicate its function in biotic stress reduction and motility. We applied a newly developed bioinformatics approach for prediction of PGPTs (PGPT-Pred), which supports the different lifestyles of the two new species and the plant growth-promoting performance of M. onobrychidis in the greenhouse trial. The intensive use of chemical fertilizers has a variety of negative effects on the environment. Increased utilization of biological nitrogen fixation (BNF) is one way to mitigate those negative impacts. In order to optimize BNF, suitable candidates for different legume species are required. Despite intensive search for new rhizobial bacteria associated with legumes, no new rhizobia have recently been identified from sainfoin (Onobrychis viciifolia). Here, we report on the discovery of two new rhizobial species associated with sainfoin, which are of high importance for the host and may help to increase sustainability in agricultural practices. We employed the combination of prediction and experiments, which is an effective way to detect promising plant growth-promoting bacteria.
豆科植物的根瘤主要栖息着根瘤菌固氮细菌。在这里,我们根据核心基因系统发育、全基因组相关性指数和泛基因组分析,提出了两种从普通苦马豆(Onobrychis viciifolia)根瘤中分离出来的新物种。Mesorhizobium onobrychidis sp. nov. 积极诱导结瘤并实现大气氮和二氧化碳固定。该物种似乎缺乏运动基因,而富含对植物生长表现有直接影响的基因。其基因组揭示了功能和促进植物生长的特征,例如一个带有高密度共生遗传特征的大型独特染色体基因组岛。Onobrychidicola muellerharveyae gen. nov. sp. nov. 被描述为新属的模式种。该物种具有独特的遗传特征和促进植物生长的特征(PGPTs),强烈表明其在减少生物胁迫和运动方面的功能。我们应用了一种新开发的生物信息学方法来预测 PGPTs(PGPT-Pred),该方法支持这两个新物种的不同生活方式以及 M. onobrychidis 在温室试验中的促进植物生长的性能。
大量使用化肥对环境有各种负面影响。增加生物固氮(BNF)的利用是减轻这些负面影响的一种方法。为了优化 BNF,需要为不同的豆科植物选择合适的候选物种。尽管人们一直在积极寻找与豆科植物相关的新根瘤菌,但最近没有从苦马豆(Onobrychis viciifolia)中发现新的根瘤菌。在这里,我们报告了两种与苦马豆相关的新根瘤菌的发现,这对宿主非常重要,可能有助于提高农业实践的可持续性。我们采用了 预测和 实验相结合的方法,这是一种检测有前途的促进植物生长的细菌的有效方法。